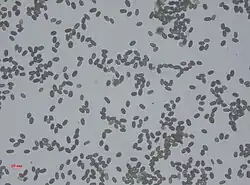

Stachybotrys
| Stachybotrys | |
|---|---|
| |
| Conidiophores of Stachybotrys chartarum with clusters of phlialides | |
| Scientific classification | |
| Kingdom: | Fungi |
| Division: | Ascomycota |
| Class: | Sordariomycetes |
| Order: | Hypocreales |
| Family: | Stachybotryaceae |
| Genus: | Corda (1837) |
| Type species | |
| Stachybotrys atrus Corda (1837)
| |
| Species | |
|
~ 50, see text | |
| Synonyms[1] | |
Stachybotrys (/ˌstækiˈbɒtrɪs/) is a genus of molds, hyphomycetes or asexually reproducing, filamentous fungi, now placed in the family Stachybotryaceae. The genus was erected by August Carl Joseph Corda in 1837. Historically, it was considered closely related to the genus Memnoniella,[2][3] because the spores are produced in slimy heads rather than in dry chains. Recently, the synonymy of the two genera is generally accepted.[4] Most Stachybotrys species inhabit materials rich in cellulose. The genus has a widespread distribution and contained about 50 species in 2008.[5] There are 88 records of Stachybotrys on Species Fungorum (in 2023), of which 33 species have DNA sequence data in GenBank. Species in the genus are commonly found in soil, plant litter (hay, straw, cereal grains, and decaying plant debris) and air and a few species have been found from damp paper, cotton, linen, cellulose-based building materials water-damaged indoor buildings, and air ducts from both aquatic and terrestrial habitats (Izabel et al. 2010;[6] Lombard et al. 2016;[7] Hyde et al. 2020a).[8]
The name of Stachybotrys is derived from the Greek words σταχυς stakhus (ear of grain, stalk, stick; metaphorically, progeny) and βότρυς botrus (cluster or bunch as in grapes, trusses).
The most infamous species, Stachybotrys chartarum (previously known as Stachybotrys atra) and Stachybotrys chlorohalonata, are known as black mold or toxic black mold in the U.S., and are frequently associated with poor indoor air quality that arises after fungal growth on water-damaged building materials.[9] Stachybotrys chemotypes are toxic, with one producing trichothecene mycotoxins including satratoxins, and another that produces atranones.[10] However, the association of Stachybotrys mold with specific health conditions is not well proven and there exists a debate within the scientific community.[11][12][13]
Conidia
Conidia are in slimy masses, smooth to coarsely rough, dark olivaceous to brownish black, obovoid, later becoming ellipsoid with age, 10–13 × 5–7 mm. Phialides are obovate or ellipsoidal, colorless early then turning to olivaceous with maturity, smooth, 12–14 × 5–7 mm, in clusters of 5 to 9 phialides. Conidiophores are simple, erect, smooth to rough, colorless to olivaceous, slightly enlarged apically, mostly unbranched but occasionally branched. Conidia of Stachybotrys are very characteristic and can be confidently identified in spore count samples. This genus is closely related to Memnoniella. Species of Memnoniella may occasionally develop Stachybotrys-like conidia, and vice versa.[14]
Detection
Four distinctive microbial volatile organic compounds (MVOCs) – 1-butanol, 3-methyl-1-butanol, 3-methyl-2-butanol, and thujopsene – were detected on rice cultures, and only one (1-butanol) was detected on gypsum board cultures.[15]
Pathogenicity
Symptoms of Stachybotrys exposure in humans
A controversy began in the early 1990s after analysis of two infant deaths and multiple cases in children from impoverished areas of Cleveland, Ohio, United States, due to pulmonary hemorrhage were initially linked to exposure to large amounts of Stachybotrys chartarum. Subsequent and extensive reanalysis of the cases by the United States Centers for Disease Control and Prevention have failed to find any link between the deaths and the mold exposure.[16][17]
Species
As accepted by Species Fungorum (as of July 2023);[18]
- Stachybotrys aksuensis J.H. Kong & T.Y. Zhang (2014)
- Stachybotrys aloicola L. Lombard & Crous (2014)
- Stachybotrys alternans Bonord. (1851)
- Stachybotrys aurantius G.L. Barron (1962)
- Stachybotrys bambusicola Rifai (1964)
- Stachybotrys biformis J.H. Kong & T.Y. Zhang (2014)
- Stachybotrys bisbyi (Sriniv.) G.L. Barron (1964)
- Stachybotrys breviuscula McKenzie (1991)
- Stachybotrys chartarum (Ehrenb.) S. Hughes (1958)
- Stachybotrys chlorohalonatus B. Andersen & Thrane (2003)
- Stachybotrys clitoriae Bat. & Peres (1960)
- Stachybotrys cordylines McKenzie (2004)
- Stachybotrys cylindrospora C.N. Jensen (1912)
- Stachybotrys dakotensis Sacc. (1917)
- Stachybotrys dolichophialis L. Lombard & Crous (2016)
- Stachybotrys echinatus (Rivolta) G. Sm. (1962)
- Stachybotrys elasticae Koord. (1907)
- Stachybotrys freycinetiae McKenzie (1991)
- Stachybotrys frondicola (K.D. Hyde, Goh, Joanne E. Taylor & J. Fröhl.) Yong Wang bis, K.D. Hyde, McKenzie, Y.L. Jiang & D.W. Li (2015)
- Stachybotrys gamsii (K.D. Hyde, Goh, Joanne E. Taylor & J. Fröhl.) Yong Wang bis, K.D. Hyde, McKenzie, Y.L. Jiang & D.W. Li (2015)
- Stachybotrys globosus P.C. Misra & S.K. Srivast. (1982)
- Stachybotrys guttulisporus Muhsin & Al-Helfi (1981)
- Stachybotrys havanensis Mercado & J. Mena (1988)
- Stachybotrys humilis Krzemien. & Badura (1954)
- Stachybotrys indicoides Yong Wang bis, K.D. Hyde, McKenzie, Y.L. Jiang & D.W. Li (2015)
- Stachybotrys indicus P.C. Misra (1975)
- Stachybotrys jiangziensis Y.M. Wu & T.Y. Zhang (2011)
- Stachybotrys kampalensis Hansf. (1943)
- Stachybotrys kapiti Whitton, McKenzie & K.D. Hyde (2001)
- Stachybotrys klebahnii G. Burchard (1930)
- Stachybotrys leprosus (R.F. Castañeda) R.F. Castañeda (2015)
- Stachybotrys levisporus (Subram.) Yong Wang bis, K.D. Hyde, McKenzie, Y.L. Jiang & D.W. Li (2015)
- Stachybotrys limonisporus L. Lombard & Crous (2016)
- Stachybotrys littoralis J.J. Xu, Y.L. Zhang & T.Y. Zhang (2014)
- Stachybotrys longistipitatus (D.W. Li, Chin S. Yang, Vesper & Haugland) D.W. Li, Chin S. Yang, Vesper & Haugland (2015)
- Stachybotrys lunzinensis Svilv. (1941)
- Stachybotrys mangiferae P.C. Misra & S.K. Srivast. (1982)
- Stachybotrys mexicanus J. Mena & Heredia (2009); Stachybotryaceae
- Stachybotrys microspora (B.L. Mathur & Sankhla) S.C. Jong & E.E. Davis (1976)
- Stachybotrys mohanramii (Manohar., D.K. Agarwal, Kunwar, Sureshk. & Sharath) Yong Wang bis, K.D. Hyde, McKenzie, Y.L. Jiang & D.W. Li (2015)
- Stachybotrys musae B.C. Samar. & Chomnunti (2021)
- Stachybotrys nepalensis (Whitton, K.D. Hyde & McKenzie) Whitton, McKenzie & K.D. Hyde (2015)
- Stachybotrys nephrodes McKenzie (1991)
- Stachybotrys nephrospora Hansf. (1943)
- Stachybotrys nielamuensis Y.M. Wu & T.Y. Zhang (2009)
- Stachybotrys oenanthes M.B. Ellis (1971)
- Stachybotrys pallescens Y.L. Jiang & T.Y. Zhang (2009)
- Stachybotrys pallidus Orpurt (1954)
- Stachybotrys palmae Pinruan (2004)
- Stachybotrys palmicola (K.D. Hyde, Goh, Joanne E. Taylor & J. Fröhl.) Yong Wang bis, K.D. Hyde, McKenzie, Y.L. Jiang & D.W. Li (2015)
- Stachybotrys palmijunci Rifai (1974)
- Stachybotrys parvisporus S. Hughes (1952)
- Stachybotrys parvus R.S. Dwivedi & B.P. Singh (1969)
- Stachybotrys proliferatus K.G. Karand., S.M. Kulk. & Patw. (1992)
- Stachybotrys punctatus (Dulym., P.F. Cannon, K.D. Hyde & Peerally) Yong Wang bis, K.D. Hyde, McKenzie, Y.L. Jiang & D.W. Li (2015)
- Stachybotrys queenslandicus Matsush. (1989)
- Stachybotrys ramosus Dorai & Vittal (1987)
- Stachybotrys reniformis Tubaki (1963)
- Stachybotrys renisporoides K.G. Karand., S.M. Kulk. & Patw. (1992)
- Stachybotrys renisporus P.C. Misra (1976)
- Stachybotrys reniverrucosus Whitton, McKenzie & K.D. Hyde (2001)
- Stachybotrys ruwenzoriensis Matsush. (1985)
- Stachybotrys sacchari (Sriniv.) G.L. Barron (1964)
- Stachybotrys sansevieriae G.P. Agarwal & N.D. Sharma (1974)
- Stachybotrys sinuatophorus Matsush. (1971)
- Stachybotrys socia (Sacc.) Sacc. (1909)
- Stachybotrys sphaerosporus Morgan-Jones & R.C. Sinclair (1980)
- Stachybotrys stilboideus Munjal & J.N. Kapoor (1969)
- Stachybotrys subcylindrosporus C.Y. Jie, Y.L. Jiang, D.W. Li, McKenzie & Yong Wang bis (2012)
- Stachybotrys subreniformis Q.R. Li & Y.L. Jiang (2011)
- Stachybotrys subsylvaticus L. Lombard & Crous (2016)
- Stachybotrys suthepensis Photita, P. Lumyong, K.D. Hyde & McKenzie (2003)
- Stachybotrys taiwanensis (Sivan. & W.H. Hsieh) Yong Wang bis, K.D. Hyde, McKenzie, Y.L. Jiang & D.W. Li (2015)
- Stachybotrys terrestris J.H. Kong & T.Y. Zhang (2007)
- Stachybotrys thaxteri D.W. Li (2011)
- Stachybotrys theobromae Hansf. (1943)
- Stachybotrys variabilis H.F. Wang & T.Y. Zhang (2009)
- Stachybotrys verrucisporus Matsush. (1985)
- Stachybotrys verrucosus Cooke & Massee (1888)
- Stachybotrys virgatus Krzemien. & Badura (1954)
- Stachybotrys voglinoi Cif. (1922)
- Stachybotrys waitakere Whitton, McKenzie & K.D. Hyde (2001)
- Stachybotrys xanthosomatis Mercado & J. Mena (1988)
- Stachybotrys xigazenensis Y.M. Wu & T.Y. Zhang (2011)
- Stachybotrys yunnanensis H.Z. Kong (1997)
- Stachybotrys yushuensis H.Q. Pan & T.Y. Zhang (2014)
- Stachybotrys zeae Morgan-Jones & Karr (1976)
- Stachybotrys zhangmuensis Y.M. Wu & T.Y. Zhang (2009)
- Stachybotrys zingiberis (V.G. Rao) Yong Wang bis, K.D. Hyde, McKenzie, Y.L. Jiang & D.W. Li (2015)
- Stachybotrys zuckii K. Matsush. & Matsush. (1995)
See also
References
Notes
- ^ "Synonymy. Current Name: Stachybotrys Corda, Icon. fung. (Prague) 1: 21 (1837)". Species Fungorum. Retrieved 19 November 2022.
- ^ Haugland, Richard A.; Vesper, Stephen J.; Harmon, Stephen M. (January–February 2001). "Phylogenetic relationships of Memnoniella and Stachybotrys species and evaluation of morphological features for Memnoniella species identification". Mycologia. 93 (1): 54–65. doi:10.2307/3761605. JSTOR 3761605. Archived (PDF) from the original on 19 July 2018 – via Zenodo.
- ^ Castlebury, Lisa A.; Rossman, Amy Y.; Sung, Gi-Ho; Hyten, Aimee S.; Spatafora, Joseph W. (August 2004). "Multigene phylogeny reveals new lineage for Stachybotrys chartarum, the indoor air fungus" (PDF). Mycological Research. 108 (8): 864–72. doi:10.1017/S0953756204000607. PMID 15449591. Archived (PDF) from the original on 3 November 2019.
- ^ Seifert, Keith A.; Gams, Gareth; Morgan-Jones, Walter; Kendrick, Bryce (2011). The Genera of Hyphomycetes. CBS Biodiversity Series. Utrecht, the Netherlands: CBS Fungal Biodiversity Centre. pp. 1–997. ISBN 978-90-70351-85-4. ISSN 1571-8859.
- ^ Paul M., Kirk; Cannon, Paul F.; Minter, David W.; Stalpers, Joost A., eds. (2008). Dictionary of the Fungi (10th ed.). Wallingford: CABI. p. 659. ISBN 978-0-85199-826-8. LCCN 2009285939.
- ^ Izabel, T.D.S.S.; Cruz, A.C.R.D.; Barbosa, F.R.; Ferreira, S.M.L.; Marques, M.F.O.; Gusmão, L.F.P. (2010). "The genus Stachybotrys anamorphic fungi) in the semi-arid region of Brazil". Rev. Bras. Bot. 33 (3): 479–487. doi:10.1590/S0100-84042010000300010.
- ^ Lombard, L.; Houbraken, J.; Decock, C.; Samson, R.A.; Meijer, M.; Réblová, M.; Groenewald, J.Z.; Crous, P.W. (2016). "Generic hyper-diversity in Stachybotriaceae". Persoonia – Molecular Phylogeny and Evolution of Fungi. 36 (1): 156–246. doi:10.3767/003158516X691582. PMC 4988370. PMID 27616791.
- ^ Hyde, Kevin D.; Norphanphoun, C.; Maharachchikumbura, S.S.N.; Bhat, D.J.; Jones, E.B.G.; Bundhun, D.; Chen, Y.J.; Bao, D.F.; Boonmee, S.; Calabon, M.S.; Chaiwan, N.; Chethana, K.W.T.; Dai, D.Q.; Dayarathne, M.C.; Devadatha, B.; Dissanayake, A.J.; Dissanayake, L.S.; Doilom, M.; Dong, W.; Fan, X.L.; Goonasekara, I.D.; Hongsanan, S.; Huang, S.K.; Jayawardena, R.S.; Jeewon, R.; Karunarathna, A.; Konta, S.; Kumar, V.; Lin, C.G.; Liu, J.K.; Liu, N.G.; Luangsa-ard, J.; Lumyong, S.; Luo, Z.L.; Marasinghe, D.S.; McKenzie, E.H.C.; Niego, A.G.T.; Niranjan, M.; Perera, R.H.; Phukhamsakda, C.; Rathnayaka, A.R.; Samarakoon, M.C.; Samarakoon, S.M.B.C.; Sarma, V.V.; Senanayake, I.C.; Shang, Q.J.; Stadler, M.; Tibpromma, S.; Wanasinghe, D.N.; Wei, D.P.; Wijayawardene, N.N.; Xiao, Y.P.; Yang, J.; Zeng, X.Y.; Zhang, S.N.; Xiang, M.M. (2020). "Refined families of Sordariomycetes". Mycosphere. 11: 305–1059. doi:10.5943/mycosphere/11/1/7. hdl:10033/622756. S2CID 219808477.
- ^ Nielsen, Kristian Fog (July 2003). "Mycotoxin production by indoor molds" (PDF). Fungal Genetics and Biology. 39 (2): 103–17. doi:10.1016/S1087-1845(03)00026-4. PMID 12781669. Archived (PDF) from the original on 10 April 2017.
- ^ Andersen, Birgitte; Nielsen, Kristian F.; Thrane, Ulf; Szaro, Tim; Taylor, John W.; Jarvis, Bruce B. (2003). "Molecular and phenotypic descriptions of Stachybotrys chlorohalonata sp. nov. and two chemotypes of Stachybotrys chartarum found in water-damaged buildings" (PDF). Mycologia. 95 (6): 1227–38. doi:10.1080/15572536.2004.11833031. PMID 21149024. S2CID 203881222. Archived (PDF) from the original on 17 September 2018 – via the University of California Berkeley.
- ^ Rudert, Amanda; Portnoy, Jay (2017). "Mold allergy: Is it real and what do we do about it?". Expert Review of Clinical Immunology. 13 (8): 823–835. doi:10.1080/1744666X.2017.1324298. PMID 28453304. S2CID 4755858.
- ^ Chang, C.; Gershwin, M. E. (2019). "The Myth of Mycotoxins and Mold Injury". Clinical Reviews in Allergy & Immunology. 57 (3): 449–455. doi:10.1007/s12016-019-08767-4. PMID 31608429. S2CID 204458646.
- ^ "You Can Control Mold | CDC". 17 May 2021.
- ^ Morey, Philip R. (2007), "Microbiological Sampling Strategies in Indoor Environments", Sampling and Analysis of Indoor Microorganisms, Hoboken, NJ, USA: John Wiley & Sons, Inc., pp. 51–74, doi:10.1002/9780470112434.ch3, ISBN 978-0-470-11243-4, retrieved 27 October 2020
- ^ Gao, Pengfei; Martin, Jennifer (June 2002). "Volatile metabolites produced by three strains of Stachybotrys chartarum cultivated on rice and gypsum board". Applied Occupational and Environmental Hygiene. 17 (6): 430–6. doi:10.1080/10473220290035462. PMID 12049433. NIOSHTIC No. 20022270.
- ^ "Case Definition for Acute Idiopathic Pulmonary Hemorrhage in Infants". National Center for Environmental Health. Archived from the original on 15 November 2001.
- ^ Centers for Disease Control and Prevention (10 March 2000). "Update: Pulmonary Hemorrhage/Hemosiderosis Among Infants — Cleveland, Ohio, 1993–1996". Morbidity and Mortality Weekly Report. 49 (9): 180–4. PMID 11795499. Archived from the original on 20 May 2016.
- ^ "Species Fungorum – Search Page – Stachybotrys". www.speciesfungorum.org. Retrieved 20 July 2023.
Further reading
- Progovitz, Richard F. (2003). Black Mold: Your Health and Your Home. The Forager Press. ISBN 978-0-9743943-9-8.
External links
- "Facts about Stachybotrys chartarum and Other Molds". Centers for Disease Control and Prevention. Archived from the original on 1 November 2019.
_S._Hughes_43158.jpg)